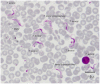

Atypical human infections by animal trypanosomes
- PMID: 24069464
- PMCID: PMC3772015
- DOI: 10.1371/journal.pntd.0002256
Atypical human infections by animal trypanosomes
Abstract
The two classical forms of human trypanosomoses are sleeping sickness due to Trypanosoma brucei gambiense or T. brucei rhodesiense, and Chagas disease due to T. cruzi. However, a number of atypical human infections caused by other T. species (or sub-species) have been reported, namely due to T. brucei brucei, T. vivax, T. congolense, T. evansi, T. lewisi, and T. lewisi-like. These cases are reviewed here. Some infections were transient in nature, while others required treatments that were successful in most cases, although two cases were fatal. A recent case of infection due to T. evansi was related to a lack of apolipoprotein L-I, but T. lewisi infections were not related to immunosuppression or specific human genetic profiles. Out of 19 patients, eight were confirmed between 1974 and 2010, thanks to improved molecular techniques. However, the number of cases of atypical human trypanosomoses might be underestimated. Thus, improvement, evaluation of new diagnostic tests, and field investigations are required for detection and confirmation of these atypical cases.
Conflict of interest statement
The authors have declared that no competing interests exist.
Figures

References
-
- Hoare CA (1972) The trypanosomes of mammals. A zoological monograph. Oxford and Edinburgh: Blackwell Scientific Publications. 769 p.
-
- Rassi A Jr, Rassi A, Marin-Nieto JA (2010) Chagas' disease. Lancet 375: 1388–1402. - PubMed
-
- Maraghi S, Wallbanks KR, Molyneux DH (1995) Oral transmission of trypanosomes of the subgenus Herpetosoma from small mammals. Parasitol Res 81: 693–695. - PubMed
-
- Gutierrez C, Desquesnes M, Touratier L, Büscher P (2010) Trypanosoma evansi: recent outbreaks in Europe. Vet Parasitol 24 174: 26–29. - PubMed
-
- Vanhamme L, Paturiaux-Hanocq F, Poelvoorde P, Nolan DP, Lins L, et al. (2003) Apolipoprotein L-I is the trypanosome lytic factor of human serum. Nature 422: 83–87. - PubMed
Publication types
MeSH terms
LinkOut - more resources
Full Text Sources
Other Literature Sources